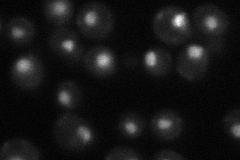
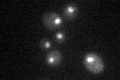

View description
Member of a complex (Isw1b) with Isw1p and Ioc4p that exhibits nucleosome-stimulated ATPase activity and acts within coding regions to coordinate transcription elongation with termination and processing, contains a PHD finger motif
Localization:
Intensity:
Fold change:
Significance:
-
C’ GFP library in SD

nucleus33.95 -
N' NOP1pr-GFP in SD

nucleus62.3209 -
N' TEF2pr-mCherry in SD

nucleus23.8856 -
N' NATIVEpr-GFP in SD
nucleus32.9477 -
N' TEF2pr-VC and Cyto-VN in SD

#N/A0 -
C’ GFP library in SD+DTT

nucleus34.541.01No -
C’ GFP library in SD+H2O2

nucleus33.130.97No -
C’ GFP library in Starvation Media
nucleus25.910.76No -
C’ GFP library on the background of Pup2-DaMP

nucleus -
C’ GFP library on the background of CCT mutant

nucleus34.63951.02004No
